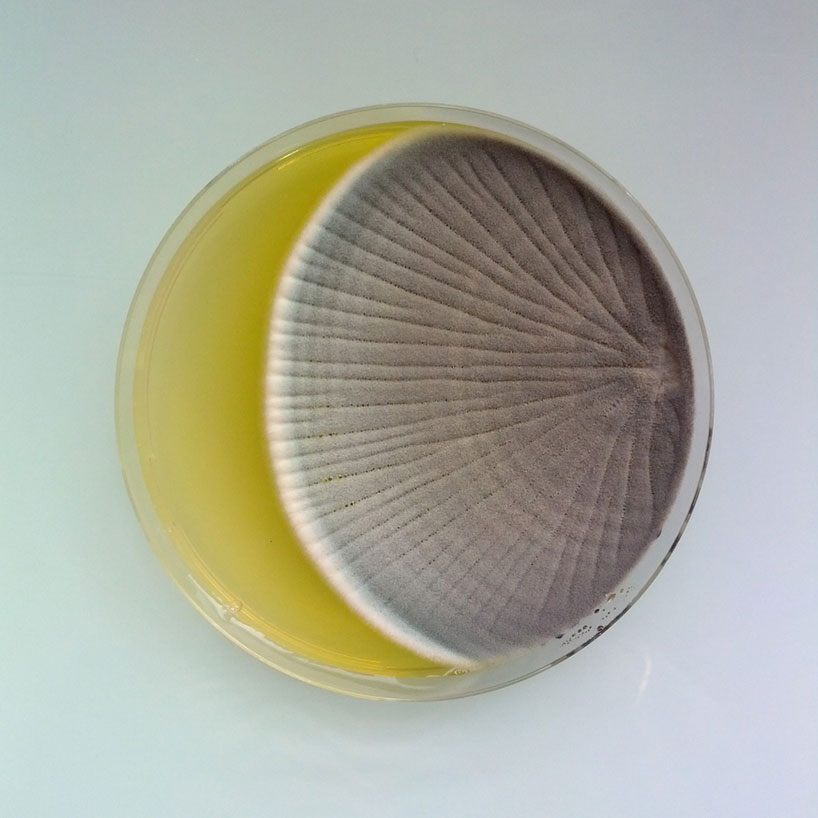

به مناسبت چهل سالهگی شرکت میرو، یک طراح اسپانیایی فونتی مدولار را برای مراسم آنها طراحی کرده است. فونتی که او برای اعداد استفاده شده در محصولات و حجمهای این شرکت در این رویداد طراحی کرده، برگرفته از فرم معماری ساختمان این شرکت است که نورگیرهایی بادگیرمانند دارد. این هویت بصری واحد هنگامی خود را بهتر نشان میدهد که عدد چهل را به صورت مجسمهای ۲ متری درست در زیر این نورگیرها قرار دادهاند و این حجم واسطی شده است برای اتصال ظاهر معماری مجموعه، به هویت گرافیکی محصولات و تبلیغات آن.

- ۱ نظر
- ۰۷ شهریور ۹۴ ، ۲۲:۴۰